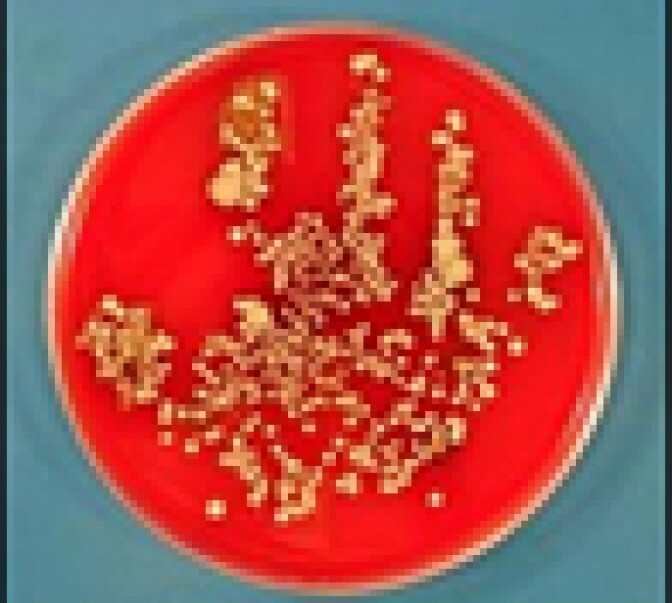
Cedars-Sinai's Hand Washing poster

Message from John Rabe With cold and flu season still upon us, we decided to re-run this show on germs. This week, hand washing, flu shots, and the new sneeze. And... oboist, super music agents and more -John
The New Sneeze
Sneezing into hands is out - into the sleeves is in. John Rabe takes an office poll to see who's up on the new sneeze.
Hand Washing
Doctor Paul Silka, chief of staff at Cedars Sinai, tells us about their hand washing campaign.
New Oboist in Town
The Los Angeles Philharmonic has a new principal oboist, 26-year-old Ariana Ghez. Queena Kim spoke to Ghez at a practice room in Disney Hall recently.
Saul Levine
John Rabe talks with LA radio legend Saul Levine. He could sell K-Mozart, the commercial classical station, for somewhere around 200-million dollars, but he won't, because he believes in local radio.
Super Agent Man
Some people underplay their accomplishments. Other people exaggerate them. All Jerry Heller has to do is tell the truth.
The 66-year-old Heller's spent his life on the business side of the music business, from bringing Elton John to America, to co-founding Ruthless Records with rapper Eazy E... The guy who helped bring you Your Song was also partly responsible for Cop Killer and Straight Outta Compton.
KPCC's Adolfo Guzman-Lopez spoke with Heller about his new memoir, Ruthless.
Space Aliens and Sea Fish
Marine biologist Milton Love tells us how tracking fish helped him understand alien abductions.
From Fallen Fruit to Jam
A few weeks ago, as the peaches ripened in Echo Park, the group Fallen Fruit held a jam session. They taught people how to make jam from fruit that grows on public property.
Tamborza
Every once in a while, to get a good story, all you have to do is get up off the couch. John got off his couch to listen to a Tamborza band playing in a neighbor's yard.
Alameda Swap Meet
The two chef-owners of La Casita Mexicana in the city of Bell take Off-Ramp producer Queena Kim shopping for little-known Mexican herbs at the Alameda Swap Meet.
SoCal Visionary
Carey McWilliams defined southern California the way Newton defined physics. People credit his writings for sparking the Chicano movement, foreshadowing the film Chinatown, and inspiring Cesar Chavez to found the United Farm Workers.
Marc Haefele (a.k.a. "The Dean of City Hall") tells us about Carey McWilliams, California chronicler ahead of his time.